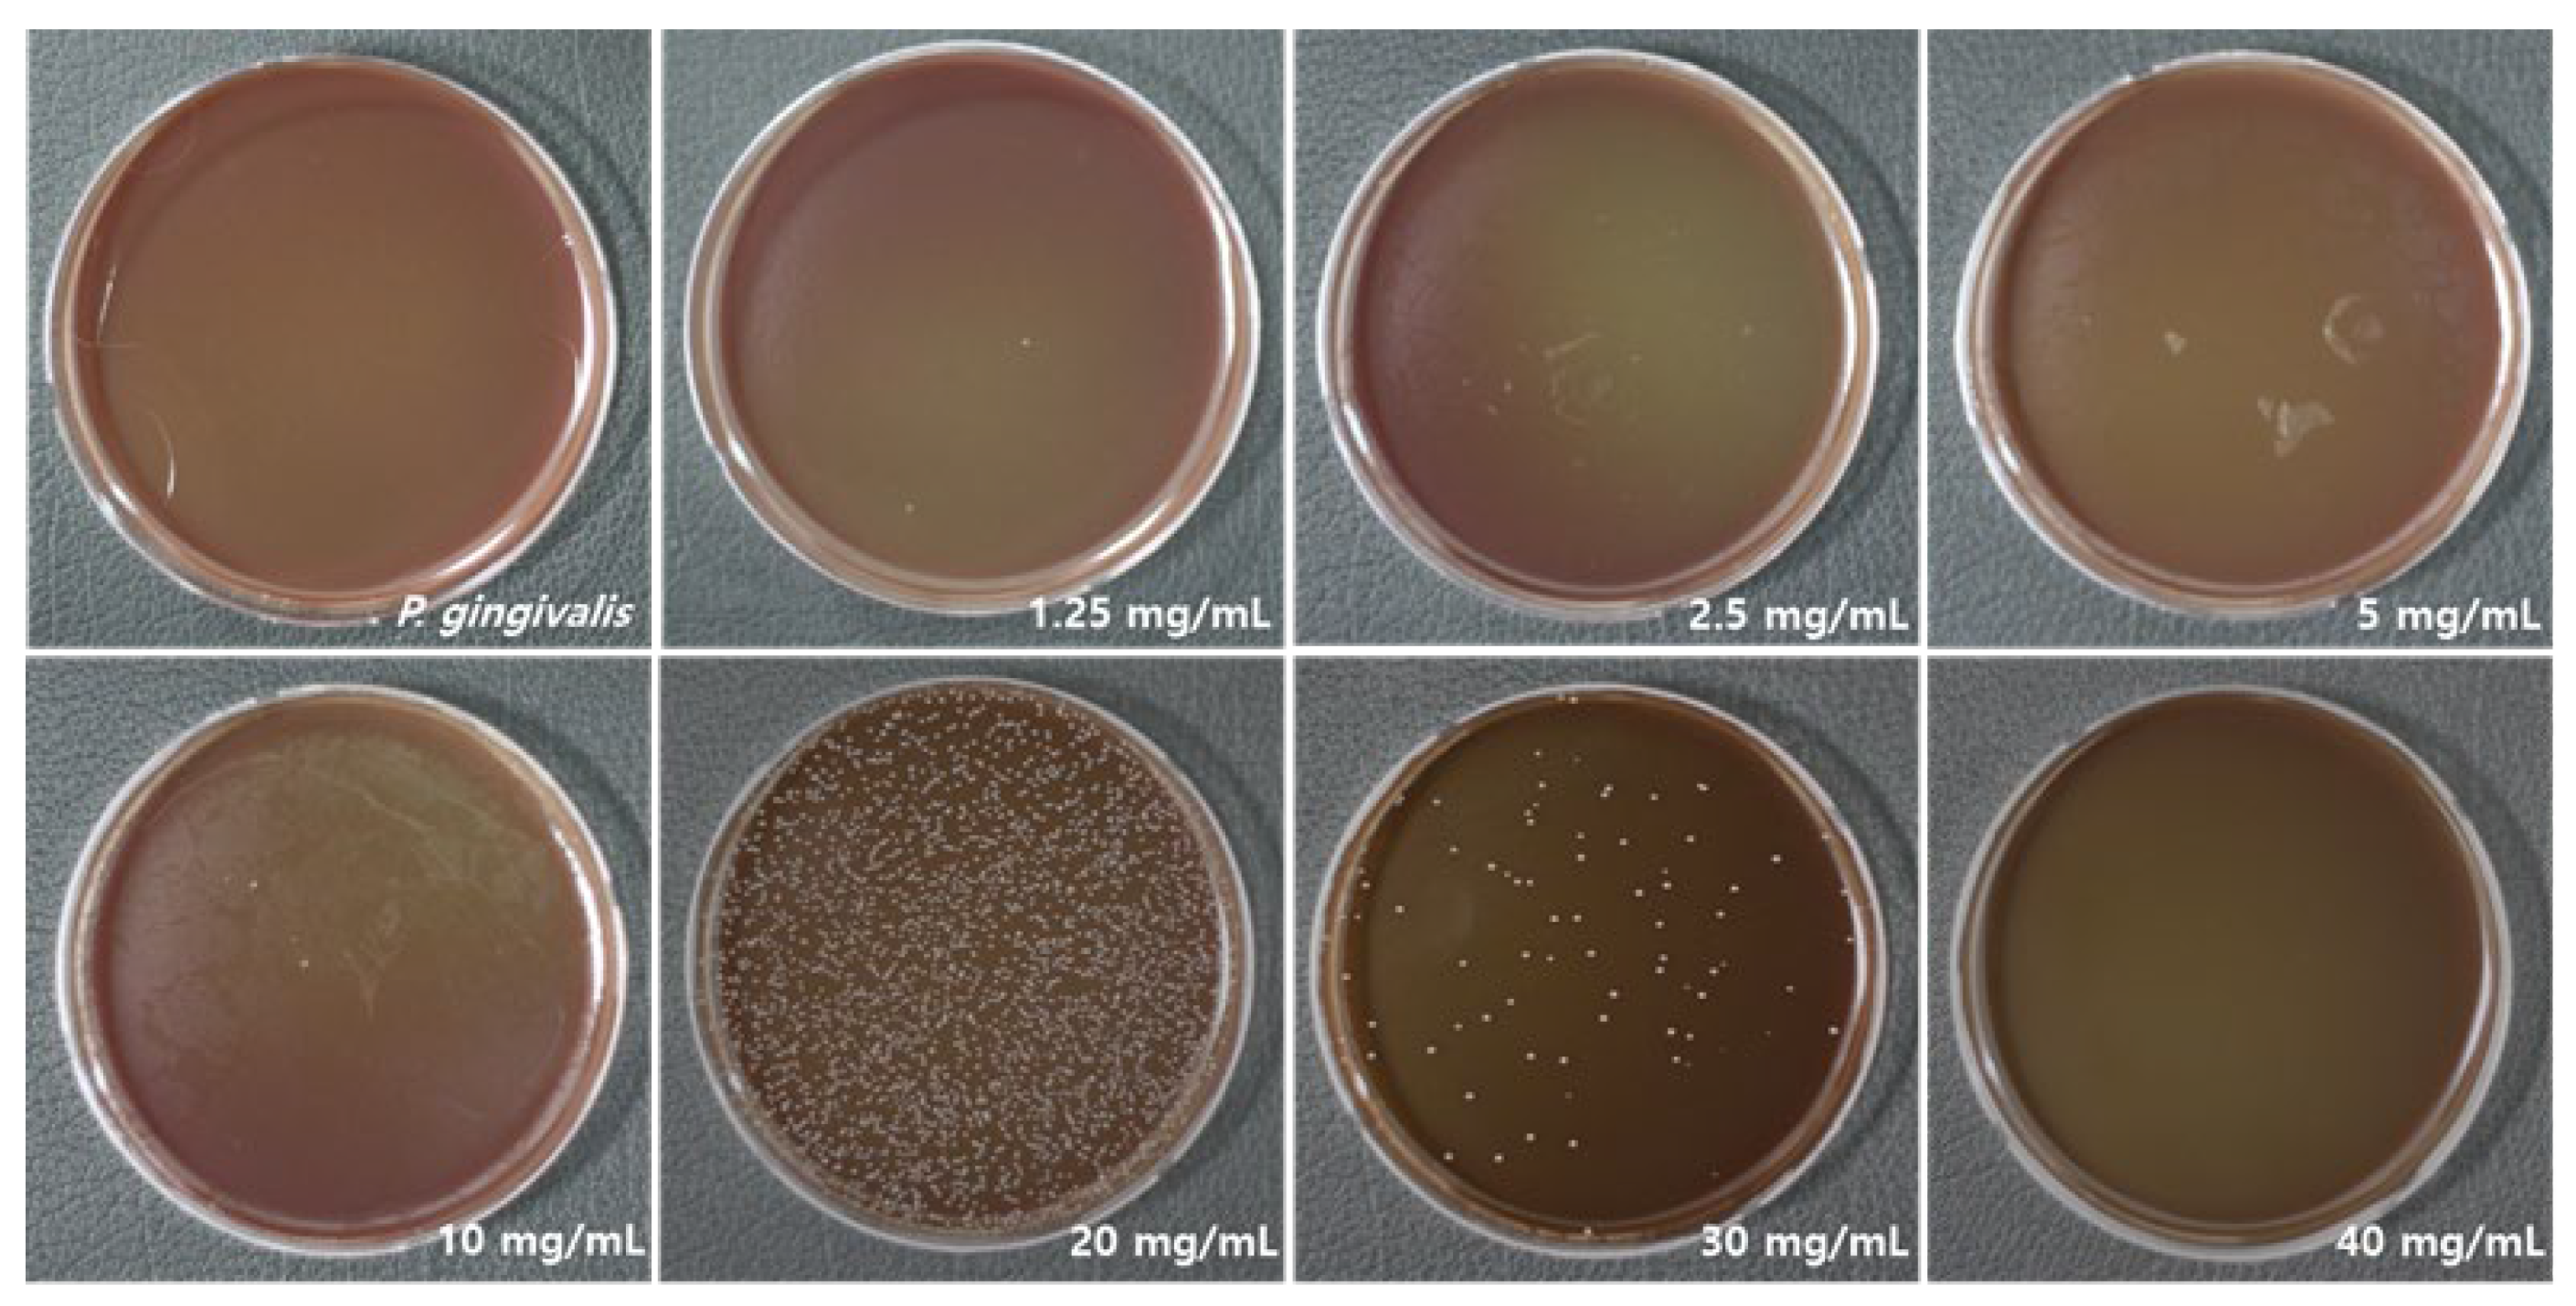
Applsci 15 09969 g001 Applsci 15 09969 g001

Abstract
Porphyromonas gingivalis (P. gingivalis), the main pathogen in periodontal disease, requires effective control to maintain oral health. Due to cytotoxicity and antimicrobial resistance associated with chemical agents, safe natural alternatives are needed. This study assessed the antibacterial activity and biological safety of Sambucus williamsii var. coreana (S. williamsii var. coreana) extract against P. gingivalis. The extract was prepared by hot-water extraction with 70% ethanol, concentrated, and freeze-dried. Antibacterial effects were tested by applying different concentrations (1, 3, 5, 10, 20, 30, and 40 mg/mL) to P. gingivalis under anaerobic conditions for 24 h, followed by colony-forming unit (CFU) counts. Cytotoxicity and morphology of human gingival fibroblasts (HGFs) were evaluated using Water-Soluble Tetrazolium Salt (WST-1) and Sulforhodamine B (SRB) assays. The extract showed dose-dependent antibacterial activity, achieving 99.99% reduction at 5 mg/mL and complete inhibition at 40 mg/mL (p < 0.05). WST-1 results indicated dose-dependent cytotoxicity, with approximately 50–57% cell viability at 10 mg/mL. SRB assay showed no significant morphological damage was observed at concentrations below 10 mg/mL, however concentrations above this level induced nuclear condensation. These findings suggest that S. williamsii var. coreana extract has strong antibacterial effects against P. gingivalis with acceptable cytocompatibility, making it a promising natural alternative to chemical antimicrobials for periodontal disease prevention and treatment.
1. Introduction
Periodontal disease is a chronic infectious disease caused by complex bacterial communities that damage periodontal structures, including the gingiva, periodontal ligament, alveolar bone, and cementum [1]. This condition is characterized by the progressive destruction of both periodontal soft and hard tissues, affecting more than 40% of the global population in the 2018 European Federation of Periodontology/American Academy of Periodontology (EFP/AAP) classification and the AAP/CDC case definitions [2]. If left untreated, it can result in tooth loss, leading to compromised masticatory function and subsequent nutritional deficiencies, which may contribute to a significant decline in quality of life and impose considerable public health and economic burdens [3]. Furthermore, severe periodontitis exhibits a bidirectional relationship with systemic conditions such as diabetes mellitus and cardiovascular disease, thereby exacerbating both oral and overall health outcomes [4]. This highlights the imperative for the development and implementation of effective preventive and therapeutic strategies for periodontal disease, emphasizing the importance of comprehensive management to preserve both oral and systemic health.
Among the key pathogens, Porphyromonas gingivalis (P. gingivalis), a member of the “red complex” along with Tannerella forsythia and Treponema denticola, is considered the most significant contributor to chronic periodontitis [5]. Periodontal tissues form a barrier to oral microbiota, and infiltration by these microbial community triggers inflammation and disease progression [6]. Holt et al. successfully induced periodontitis in rhesus monkeys by inoculating P. gingivalis into the subgingival microbiota, confirming its pathogenic role [7]. Colonization by P. gingivalis impairs host innate immunity, promotes inflammation, and contributes to microbial dysbiosis by disrupting host-microbe homeostasis and interacting synergistically with other oral bacteria [8,9]. Furthermore, its presence in fluids, such as synovial fluid and plasma, suggests associations with systemic conditions [10]. Host–pathogen interactions involving P. gingivalis might be implicated in the pathogenesis of Alzheimer’s disease, diabetes, and cardiovascular conditions, and in exacerbating central nervous system inflammation [11,12].
Conventional periodontal therapies, such as scaling and root planning, can be limited by restricted access, making complete pathogen elimination challenging and highlighting the need for adjunctive therapies [13]. Although topical and systemic antibiotics are effective in controlling oral biofilms, their use may lead to adverse effects such as antibiotic resistance and gastrointestinal disturbances [14,15].
Chlorhexidine (CHX) is widely used as a topical antiseptic antibacterial agents. However, Coelho et al. demonstrated that CHX exhibits cytotoxicity toward Human gingival fibroblasts (HGFs) even at concentrations below those typically used in the treatment of periodontal disease. Its cytotoxic effects increase dose-dependently, becoming especially pronounced at concentrations above 0.12% [16]. HGFs among the most abundant resident cells in the oral mucosa, play a key immunoregulatory role in periodontal health. Beyond producing extracellular matrix (ECM) components, they express cell surface proteins such as CD14, toll-like receptor-4 (TLR4), and myeloid differentiation protein 2 (MD-2), and secrete inflammatory cytokines such as IL-6 in response to infection, contributing to immune reactions in periodontitis [17]. Therefore, it is essential to develop new therapeutic agents that minimize damage to HGFs while maintaining antimicrobial efficacy. In this context, there is growing interest in developing natural antimicrobial agents that are both effective and biologically safe, avoiding chemically induced adverse effects.
Sambucus williamsii var. coreana has been traditionally used for centuries in treating bone fractures, rheumatoid arthritis, inflammation-related gastrointestinal diseases, and kidney diseases, and is well recognized for its anti-inflammatory and antioxidant properties [18]. This plant contains a wide range of bioactive compounds, including flavonoids (e.g., quercetin, rutin), saccharides (e.g., glucose, fructose), glycosides (e.g., (−)-olivil-9′-O-β-D-glucopyranoside, glochidioboside), terpenoids (e.g., β-sitosterol), phenylpropanoids (e.g., (+)-pinoresinol, lariciresinol), alkaloids, phenols, and phenolic glycosides, which contribute to its applications in food, pharmaceutical, horticultural, cosmetic, and ornamental industries [19]. Notably, quercetin and rutin possess antibacterial and anti-inflammatory activities and have potential to inhibit periodontal pathogens such as P. gingivalis, while (+)-pinoresinol and glochidioboside have demonstrated antifungal activity by disrupting microbial membranes [19,20]. Extracts of S. williamsii var. coreana have been reported to be safe at various concentrations; however, further toxicity studies are required to determine precise safety thresholds in HGFs [21]. Given these properties, S. williamsii var. coreana represents a promising natural antibacterial candidate to address cytotoxicity concerns associated with CHX, offering a potential alternative for the management of periodontal disease.
This study aimed to evaluate the potential of S. williamsii var. coreana as a natural adjunctive agent for managing periodontal disease. Specifically, its antimicrobial effects against the primary pathogen in periodontitis (P. gingivalis) were assessed, and its cytotoxicity toward HGFs (the predominant resident cells in periodontal tissues) was assessed to evaluate its suitability as a safe alternative to conventional chemical antimicrobials.
2. Materials and Methods
2.1. Extraction of S. williamsii var. coreana
To obtain the powdered extract of S. williamsii var. coreana, plant material supplied by Cheongmyeong Co., Ltd. (Goesan, Chungcheongbuk-do, Republic of Korea) was extracted in 70% ethanol at a ratio of 1:5 at 60 °C for 12 h. The filtrate was concentrated via rotary vacuum evaporation (N-1300E.V.S., EYELA, Rikakikai Co., Ltd., Tokyo, Japan) and subsequently lyophilized at −80 °C using a freeze dryer (Ilshin Lab Co., Ltd., Yangju-si, Republic of Korea). The sample was dissolved in 1 mL of dimethyl sulfoxide (DMSO) to a final stock concentration of 100 mg/mL, diluted, and stored at −20 °C.
2.2. Bacterial Strain and Culture Conditions
P. gingivalis (KCTC 5352), obtained from the Korean Collection for Type Cultures (KCTC, KRIBB, Jeollabuk-do, Republic of Korea), was grown under anaerobic conditions at 37 °C for 24 h in tryptic soy broth (Difco™, Thermo Fisher Scientific, Waltham, MA, USA) enriched with yeast extract (5 mg/mL), L-cysteine hydrochloride (5 μg/mL), hemin (1 μg/mL), and vitamin K1 (0.2 μg/mL). For maintenance, cultures were also propagated on tryptic soy blood agar plates containing 5% defibrinated sheep blood.
2.3. Inhibition of Bacterial Growth
The antimicrobial efficacy of S. williamsii var. coreana extract against P. gingivalis was evaluated by measuring viable bacterial counts across various concentrations. A 100 μL liquid medium containing 1 × 105 colony-forming units (CFU)/mL of P. gingivalis was mixed with the extract at concentrations of 1.25, 2.5, 5, 10, 20, 30, and 40 mg/mL and incubated anaerobically for 24 h. To study bacterial morphology and distribution, 1 mL of each culture was inoculated onto tryptic soy blood agar plates and incubated anaerobically for another 24 h. The CFU counts were used to determine the extract’s antimicrobial activity. All analyses were performed in three independent replicates to ensure statistical robustness.
2.4. Cytotoxicity Evaluation
The Water-Soluble Tetrazolium Salt (WST-1) assay [22] was employed to assess cytotoxicity. HGFs were purchased from the American Type Culture Collection (ATCC, Manassas, VA, USA). Cells were maintained in Dulbecco’s Modified Eagle’s Medium (DMEM; Gibco, Grand Island, NY, USA) containing 10% fetal bovine serum (FBS; Gibco, Grand Island, NY, USA) and 1% penicillin–streptomycin (Gibco, Grand Island, NY, USA), under conditions of 37 °C and 5% CO2. For the assay, cells were plated in 96-well plates at a density of 1 × 105 cells/cm2 and incubated for 24 h, followed by treatment with the extract at 1, 3, 5, 10, 20, 30, and 40 mg/mL for an additional 3 h. Following treatment, the WST-1 solution was introduced into each well, and the plates were maintained for 2 h under identical incubation conditions. Cytotoxicity and cell viability at 3, 6, and 24 h were determined by measuring the absorbance at 450 nm with a microplate reader (Multiskan FC, Thermo Fisher Scientific). Each experiment was performed in triplicate to ensure statistical accuracy.
2.5. Cell Viability Analysis
Cell viability and morphological changes were assessed using the Sulforhodamine B (SRB) assay [23]. HGFs were seeded at 1 × 105 cells/cm2 in 35 mm culture dishes and incubated for 24 h at 37 °C in a 5% CO2 incubator. Following 24 h treatment with varying concentrations of S. williamsii var. coreana extract in DMEM, cells were fixed with 500 μL of 4% paraformaldehyde for 30 min. After two washes, cells were stained with SRB for 1 h. Excess dye was removed with 1% acetic acid, and samples were air-dried. Stained cells were visualized under a light microscope (OLYMPUS Optical Co., Melville, NY, USA) equipped with a digital camera at 200× magnification. To increase reliability, all experiments were repeated three times under identical conditions.
2.6. Statistical Analysis
The effects of S. williamsii var. coreana extract on P. gingivalis inhibition and HGF cell viability were statistically assessed with SPSS (v24.0; SPSS Inc., Chicago, IL, USA). One-way ANOVA was applied, followed by Duncan’s multiple range test for post hoc analysis, with a significance threshold set at p < 0.05.
3. Results
3.1. Antibacterial Activity
To visually confirm the antibacterial activity of S. williamsii var. coreana against P. gingivalis, undiluted bacterial suspensions were plated, and the activity increased in a concentration-dependent manner (Figure 1). At higher concentrations, bacterial growth was progressively suppressed, with a statistically significant reduction already evident at 5 mg/mL, where a 99.99% decrease in viable bacterial count was observed compared to the control group (p < 0.05). As the concentration increased to 30 mg/mL, the antibacterial effect remained strong, reaching near-complete suppression. At the highest tested concentration of 40 mg/mL, complete eradication of P. gingivalis was achieved, as confirmed by both logarithmic bacterial counts and statistical analysis (p < 0.05). Although both 30 mg/mL and 40 mg/mL demonstrated potent antibacterial activity, the difference in their inhibitory effects was not statistically significant. Nevertheless, complete eradication was confirmed at 40 mg/mL (Table 1, p < 0.05). There was no statistically significant difference in the concentration of RVS extract between 10 mg/mL and 20 mg/mL.
Figure 1.
Growth inhibition of P. gingivalis by Sambucus williamsii var. coreana extract.
Table 1.
Antibacterial effect of Sambucus williamsii var. coreana extract against P. gingivalis at various concentrations.
3.2. Toxic Effects on Cell Viability
Cytotoxicity results assessed via the WST-1 assay are illustrated in Figure 2, demonstrating a clear concentration-dependent decrease in the viability of HGF cells (p < 0.05). As the concentration of Sambucus williamsii var. coreana extract increased, cell survival progressively declined, indicating dose-dependent toxicity. Specifically, at 10 mg/mL, cell viability was reduced to approximately 56% after 3 h of exposure, 57% after 6 h, and 51% after 24 h, values which closely approximate the half maximal inhibitory concentration (IC50) for this cell line. These data suggest that the cytotoxic threshold lies near this concentration. Furthermore, the reduction in cell viability was more significantly impacted by increasing extract concentration than by the length of exposure time, underscoring the predominant role of dosage in mediating cytotoxic effects. At concentrations exceeding 20 mg/mL, a pronounced suppression of HGFs proliferation was observed, confirming marked cytotoxicity at higher extract levels. This indicates higher doses substantially inhibit cell growth and survival, which has important implications for balancing antimicrobial efficacy with cellular safety.
Figure 2.
Viability of HGF cells following treatment with Sambucus williamsii var. coreana extract. * Significance was assessed using one-way ANOVA. Different letters (a, b, c, d, e, f, g, and h) indicate significant group differences based on Duncan’s post hoc test (p < 0.05).
3.3. Cell Morphology and Growth
Morphological alterations of HGF cells in response to S. williamsii var. coreana extract were evaluated across varying concentrations. As depicted in Figure 3, treatment with 10 mg/mL resulted in a moderate reduction in cell density, without observable cell detachment or overt cytotoxicity, suggesting limited impact on cellular proliferation. At 20 mg/mL, more pronounced morphological changes were evident, including decreased proliferative activity accompanied by nuclear condensation, indicative of early cytotoxic responses and potential apoptotic initiation. Exposure to 30 mg/mL induced severe cytotoxic effects, characterized by marked cellular shrinkage, nuclear fragmentation, and degradation, consistent with significant loss of cell viability. These findings demonstrate a clear concentration-dependent progression of cytotoxic morphological changes in HGF cells, underscoring the dose-dependent cytotoxic potential of S. williamsii var. coreana extract.
Figure 3.
Morphological changes and proliferation of HGFs following treatment with varying concentrations of Sambucus williamsii var. coreana extract under a digital light microscope at 200× magnification.
4. Discussion
Periodontal disease is a prevalent chronic inflammatory condition that significantly affects the supporting structures of the teeth. A meta-analysis of studies conducted between 2011 and 2020 reported an overall prevalence of periodontitis of approximately 62%, with severe cases affecting approximately 24% of the population [24].
P. gingivalis, a primary etiological agent in the onset and progression of periodontitis, is an opportunistic pathogen adept at colonizing the oral epithelium and thriving in anaerobic subgingival environments [25]. 85.75% of subgingival plaque samples were detected from patients with chronic periodontitis, compared to only ~25% in individuals without oral disease [26,27]. Moreover, P. gingivalis plays a pivotal role in perpetuating inflammation, contributing to tissue destruction and alveolar bone loss, thereby accelerating disease progression [28].
Current treatment strategies for periodontitis include maintaining oral hygiene, professional plaque removal, and targeted antibiotic therapy [29]. Antimicrobial agents are frequently used as adjuncts to mechanical debridement, helping to reduce oral biofilm without disrupting the natural microbial ecosystem [30]. Antibiotics use can lead to microbial resistance, an imbalance of the oral microbiome, and systemic side effects. In addition, antiseptic antibacterial agents such as chlorhexidine are associated with undesirable adverse effects, including tooth staining, xerostomia, taste alteration, burning sensations, parotid gland swelling, and oral dysesthesia. Therefore, there is a growing need for safer and more biocompatible alternatives [31,32,33].
Several alternative therapeutic strategies have been investigated to overcome the limitations associated with conventional periodontal treatments, including mechanical debridement, topical or systemic antibiotic administration, and surgical intervention. These alternative approaches encompass photodynamic antimicrobial therapy [34], the utilization of natural compounds such as polyphenols [35], and the incorporation of probiotics as adjunctive agents in periodontal therapy. These approaches can restore the balance of the oral microbiome, reduce inflammation, and improve the clinical outcome of periodontitis [36]. Recent research on the prevention and treatment of periodontal disease has focused on developing therapeutic strategies targeting key pathogenic microorganisms, and natural products are emerging as promising candidates for new antimicrobial agents. These offer potential benefits in controlling periodontal pathogens and are positioned as alternatives to conventional chemical treatments [37]. Accordingly, interest in natural antimicrobial agents that can target P. gingivalis, the main pathogen of periodontitis, has increased, and research is being conducted on the development of new antimicrobial agents based on natural products.
The antibacterial activity of garlic extract against P. gingivalis was reported to have inhibited biofilm formation by approximately 90% at 16 mg/mL, indicating that it not only had a direct bactericidal effect but also had the effect of inhibiting the expression of pathogenic factors [38]. Similarly, the extract of Moringa oleifera seeds inhibited P. gingivalis biofilm formation at a concentration of 25 mg/mL, while the extract of red pomegranate albedo showed inhibitory activity at 12.5 mg/mL [39]. In addition, Ruta angustifolia extract, which inhibits the attachment and formation of P. gingivalis, showed strong antibacterial activity against P. gingivalis at 6.25 mg/mL and was confirmed to have the effect of inducing cell wall damage [40].
Despite such promising findings, research remains limited regarding the biological safety and optimal dosing of natural extracts, particularly in terms of cytotoxicity evaluation. Therefore, this study aimed to evaluate both the antimicrobial efficacy of S. williamsii var. coreana extract against P. gingivalis and its cytotoxicity on HGFs, which are essential for periodontal tissue regeneration. The results showed that the S. williamsii var. coreana extract used in this study inhibited P. gingivalis by approximately 99.99% at a concentration of 5 mg/mL, demonstrating a significant antibacterial effect even at lower concentrations than previously reported natural extracts. Complete eradication of P. gingivalis was observed at 40 mg/mL of S. williamsii var. coreana extract, demonstrating excellent antibacterial effects in a dose-dependent manner. Comparable results were reported by Yoon et al., who found that Lespedeza cuneata extract exhibited 99.98% efficacy at 5 mg/mL and complete eradication at 40 mg/mL [41]. These results suggest that S. williamsii var. coreana has a potent direct antibacterial effect against major periodontal pathogens and can be evaluated as a promising candidate for the development of natural-based antibacterial agents for the prevention and treatment of periodontitis.
HGFs are central to tissue repair, remodeling, and the maintenance of periodontal homeostasis [17]. During periodontitis, HGFs mediate inflammatory responses, interact with invading pathogens, and influence adjacent cells through inflammatory signaling, making them crucial targets for therapeutic intervention [42]. Therefore, any candidate compound for clinical application must be non-toxic to HGFs and demonstrate biocompatibility.
In this study, WST-1 analysis revealed that cytotoxicity was influenced by concentration than exposure time to a greater extent. The IC50 of S. williamsii var. coreana extract was identified as 10 mg/mL. Concentrations exceeding this level significantly inhibited HGF proliferation in a dose-dependent manner. SRB staining revealed that cell morphological changes were concentration dependent. At 10 mg/mL, a reduction in cell density was noted; however, no morphological abnormalities were observed, such as altered intercellular spacing, reduced adhesion, or signs of cell death (such as membrane disruption, cytoplasmic contraction, or apoptotic body formation). However, at concentrations ≥20 mg/mL, nuclear condensation became apparent, indicating the onset of cytotoxicity. These findings suggest that S. williamsii var. coreana extract is biologically safe for HGFs at concentrations up to 10 mg/mL. Based on these results, although complete eradication of P. gingivalis was achieved at a concentration of 40 mg/mL, this concentration exhibited cytotoxic effects on HGFs. Therefore, a concentration of 10 mg/mL, which demonstrated 99.99% antibacterial activity without inducing cytotoxicity, appears to be the most appropriate and optimal concentration for application. This study provides scientific evidence supporting both the antibacterial efficacy and cytotoxicity profile of S. williamsii var. coreana extract, offering foundational data for developing natural antibacterial agents for periodontitis prevention and treatment. However, a key limitation is the focus on a single pathogen, P. gingivalis, despite its well-established role in periodontitis. Broader investigations are needed to evaluate the effects against diverse oral pathogens and microbial communities. Furthermore, the active components responsible for antimicrobial action remain unidentified, and their underlying mechanisms require elucidation. In addition, it will be necessary to evaluate whether direct treatment of periodontal disease is possible through studies confirming the anti-biofilm formation and anti-inflammatory activity S. williamsii var. coreana extract. Furthermore, future clinical investigations comparing its efficacy with established antiseptic antibacterial compounds are warranted to assess its clinical effectiveness and potential as a therapeutic alternative. Since cytotoxicity was assessed using only HGF cells, future studies should explore interactions with other periodontal cell types to comprehensively evaluate biocompatibility. Continued research into biocompatibility, sustainability, and efficacy may support the clinical application of this extract as a novel therapeutic strategy for periodontal disease.
5. Conclusions
S. williamsii var. coreana extract exhibited potent antibacterial activity against P. gingivalis, showing a 99.99% reduction at 5 mg/mL and complete eradication at 40 mg/mL. However, cytotoxicity assessments demonstrated a concentration-dependent decline in HGF viability, with morphological alterations observed at concentrations above 10 mg/mL. Although a concentration of 40 mg/mL achieved a complete bactericidal effect, it simultaneously caused significant cytotoxicity in HGFs. Accordingly, a concentration of 10 mg/mL is considered optimal, exhibiting potent antibacterial efficacy without cytotoxic effects. These results suggest that the extract holds promise as a natural oral antimicrobial and may serve as a safer, biocompatible alternative to traditional antibiotics or chemical rinses for preventing and managing periodontitis.
Author Contributions
Conceptualization, G.-C.K. and S.-H.N.; data curation, H.-J.Y. and S.-H.N.; methodology, H.-J.Y. and S.-H.N.; resources, H.-J.Y. and G.-C.K.; supervision, S.-H.N. and G.-C.K.; validation, S.-H.N. and H.-J.Y.; writing the original draft, H.-J.Y. and S.-H.N.; writing—review and editing, S.-H.N. and G.-C.K. All authors have read and agreed to the published version of the manuscript.
Funding
This research received no external funding.
Institutional Review Board Statement
Not applicable.
Informed Consent Statement
Not applicable.
Data Availability Statement
The original contributions presented in this study are included in the article. Further inquiries can be directed to the corresponding authors.
Conflicts of Interest
The authors declare no conflicts of interest.
References
- Patini, R.; Staderini, E.; Lajolo, C.; Lopetuso, L.; Mohammed, H.; Rimondini, L.; Rocchetti, V.; Franceschi, F.; Cordaro, M.; Gallenzi, P. Relationship between oral microbiota and periodontal disease: A systematic review. Eur. Rev. Med. Pharmacol. Sci. 2018, 22, 5575–5588. [Google Scholar] [CrossRef]
- Germen, M.; Baser, U.; Lacin, C.C.; Fıratlı, E.; İşsever, H.; Yalcin, F. Periodontitis prevalence, severity, and risk factors: A comparison of the AAP/CDC case definition and the EFP/AAP classification. Int. J. Environ. Res. Public Health 2021, 18, 3459. [Google Scholar] [CrossRef] [PubMed]
- Nascimento, G.G.; Alves-Costa, S.; Romandini, M. Burden of severe periodontitis and edentulism in 2021, with projections up to 2050: The global burden of disease 2021 study. J. Periodontal Res. 2024, 59, 823–867. [Google Scholar] [CrossRef] [PubMed]
- Hickey, N.A.; Shalamanova, L.; Whitehead, K.A.; Dempsey-Hibbert, N.; van der Gast, C.; Taylor, R.L. Exploring the putative interactions between chronic kidney disease and chronic periodontitis. Crit. Rev. Microbiol. 2020, 46, 61–77. [Google Scholar] [CrossRef]
- Darveau, R.P.; Hajishengallis, G.; Curtis, M.A. Porphyromonas gingivalis as a potential community activist for disease. J. Dent. Res. 2012, 91, 816–820. [Google Scholar] [CrossRef]
- Tatakis, D.N.; Kumar, P.S. Etiology and pathogenesis of periodontal diseases. Dent. Clin. N. Am. 2005, 49, 491–516. [Google Scholar] [CrossRef]
- Holt, S.C.; Ebersole, J.; Felton, J.; Brunsvold, M.; Kornman, K.S. Implantation of bacteroides gingivalis in nonhuman primates initiates progression of periodontitis. Science 1988, 239, 55–57. [Google Scholar] [CrossRef]
- Lorenzi, C.; Lio, F.; Mazzetti, V.; Carosi, P.; Lamelza, S.; Pistoia, E.S.; Pica, F.; Gaziano, R. Synergistic effect of metronidazole and chlorhexidine against Porphyromonas gingivalis Growth: An In Vitro Study. Dent. J. 2024, 12, 307. [Google Scholar] [CrossRef]
- Wang, Q.; Wang, B.Y.; Pratap, S.; Xie, H. Oral microbiome associated with differential ratios of Porphyromonas gingivalis and Streptococcus cristatus. Microbiol. Spectr. 2024, 12, e0348223. [Google Scholar] [CrossRef]
- Kriauciunas, A.; Gleiznys, A.; Gleiznys, D.; Januzis, G. The influence of Porphyromonas gingivalis bacterium causing periodontal disease on the pathogenesis of rheumatoid arthritis: Systematic review of literature. Cureus 2019, 11, e4775. [Google Scholar] [CrossRef]
- Carter, C.J.; France, J.; Crean, S.; Singhrao, S.K. The Porphyromonas gingivalis/host interactome shows enrichment in GWASdb genes related to Alzheimer’s disease, diabetes and cardiovascular diseases. Front. Aging Neurosci. 2017, 9, 408. [Google Scholar] [CrossRef] [PubMed]
- Dioguardi, M.; Crincoli, V.; Laino, L.; Alovisi, M.; Sovereto, D.; Mastrangelo, F.; Russo, L.L.; Muzio, L.L. The role of periodontitis and periodontal bacteria in the onset and progression of Alzheimer’s disease: A systematic review. J. Clin. Med. 2020, 9, 495. [Google Scholar] [CrossRef] [PubMed]
- Umeda, M.; Takeuchi, Y.; Noguchi, K.; Huang, Y.; Koshy, G.; Ishikawa, I. Effects of nonsurgical periodontal therapy on the microbiota. Periodontology 2000 2004, 36, 98–120. [Google Scholar] [CrossRef] [PubMed]
- Feres, M.; Figueiredo, L.C.; Soares, G.M.; Faveri, M. Systemic antibiotics in the treatment of periodontitis. Periodontology 2000 2015, 67, 131–186. [Google Scholar] [CrossRef]
- Carcuac, O.; Derks, J.; Charalampakis, G.; Abrahamsson, I.; Wennström, J.; Berglundh, T. Adjunctive systemic and local antimicrobial therapy in the surgical treatment of peri-implantitis: A randomized controlled clinical trial. J. Dent. Res. 2016, 95, 50–57. [Google Scholar] [CrossRef]
- Coelho, A.S.; Laranjo, M.; Gonçalves, A.C.; Paula, A.; Paulo, S.; Abrantes, A.M.; Caramelo, F.; Ferreira, M.M.; Silva, M.J.; Carrilho, E.; et al. Cytotoxic effects of a chlorhexidine mouthwash and of an enzymatic mouthwash on human gingival fibroblasts. Odontology 2020, 108, 260–270. [Google Scholar] [CrossRef]
- Ara, T.; Kurata, K.; Hirai, K.; Uchihashi, T.; Uematsu, T.; Imamura, Y.; Furusawa, K.; Kurihara, S.; Wang, P.L. Human gingival fibroblasts are critical in sustaining inflammation in periodontal disease. J. Periodontal Res. 2009, 44, 21–27. [Google Scholar] [CrossRef]
- Xiao, H.H.; Zhang, Y.; Cooper, R.; Yao, X.S.; Wong, M.S. Phytochemicals and potential health effects of Sambucus williamsii hance (Jiegumu). Chin. Med. 2016, 11, 36. [Google Scholar] [CrossRef]
- Waswa, E.N.; Li, J.; Mkala, E.M.; Wanga, V.O.; Mutinda, E.S.; Nanjala, C.; Odago, W.O.; Katumo, D.M.; Gichua, M.K.; Gituru, R.W.; et al. Ethnobotany, phytochemistry, pharmacology, and toxicology of the genus Sambucus L. (Viburnaceae). J. Ethnopharmacol. 2022, 292, 115102. [Google Scholar] [CrossRef]
- Choi, H.M.; Lee, J.Y.; Chang, Y.S.; Woo, E.R.; Lee, D.G. Isolation of (-)-olivil-9′-O-β-d-glucopyranoside from Sambucus williamsii and its antifungal effects with membrane-disruptive action. Biochim. Biophys. Acta 2013, 1828, 2002–2006. [Google Scholar] [CrossRef]
- Lee, S.J.; Lee, H.J.; Kim, J.H. Antioxidative activity of extracts from Sambucus williamsii var. Coreana. Korean J. Plant Res. 2012, 25, 363–371. [Google Scholar] [CrossRef]
- Ngamwongsatit, P.; Banada, P.P.; Panbangred, W.; Bhunia, A.K. WST-1-based cell cytotoxicity assay as a substitute for MTT-based assay for rapid detection of toxigenic Bacillus species using CHO cell line. J. Microbiol. Methods 2008, 73, 211–215. [Google Scholar] [CrossRef]
- Park, K.H.; Choi, J.H.; Song, Y.S.; Kim, G.C.; Hong, J.W. Ethanol extract of asiasari radix preferentially induces apoptosis in G361 human melanoma cells by differential regulation of p53. BMC Complement. Altern. Med. Med. 2019, 19, 231. [Google Scholar] [CrossRef] [PubMed]
- Tonetti, M.S.; Jepsen, S.; Jin, L.; Otomo-Corgel, J. Impact of the global burden of periodontal diseases on health, nutrition, and well-being of mankind: A call for global action. J. Clin. Periodontol. 2017, 44, 456–462. [Google Scholar] [CrossRef] [PubMed]
- Harding, A.; Robinson, S.; Crean, S.K.; Singhrao, S. Can better management of periodontal disease delay the onset and progression of Alzheimer’s disease. J. Alzheimer’s Dis. 2017, 58, 337–348. [Google Scholar] [CrossRef] [PubMed]
- Griffen, A.L.; Becker, M.R.; Lyons, S.R.; Moeschberger, M.L.; Leys, E.J. Prevalence of Porphyromonas gingivalis and periodontal health status. J. Clin. Microbiol. 1998, 36, 3239–3242. [Google Scholar] [CrossRef]
- How, K.Y.; Song, K.P.; Chan, K.G. Porphyromonas gingivalis: An overview of periodontopathic pathogen below the gum line. Front. Microbiol. 2016, 7, 53. [Google Scholar] [CrossRef]
- Hajishengallis, G. Immunomicrobial pathogenesis of periodontitis: Keystones, pathobionts, and host response. Trends Immunol. 2014, 35, 3–11. [Google Scholar] [CrossRef]
- Mann, J.; Bernstein, Y.; Findler, M. Periodontal disease and its prevention, by traditional and new avenues. Exp. Ther. Med. 2019, 19, 1504–1506. [Google Scholar] [CrossRef]
- Allaker, R.P.; Stephen, A.S. Use of probiotics and oral Health. Curr. Oral Health Rep. 2017, 4, 309–318. [Google Scholar] [CrossRef]
- Slots, J.; Rams, T.E. Antibiotics in periodontal therapy: Advantages and disadvantages. J. Clin. Periodontol. 1990, 17, 479–493. [Google Scholar] [CrossRef] [PubMed]
- Lestari, K.D.; Dwiputri, E.; Tan, G.H.K.; Sulijaya, B.; Soeroso, Y.; Natalina, N.; Harsas, N.A.; Takahashi, N. Exploring the antibacterial potential of Konjac glucomannan in periodontitis: Animal and in vitro studies. Medicina 2023, 59, 1778. [Google Scholar] [CrossRef] [PubMed]
- Brookes, Z.L.S.; Bescos, R.; Belfield, L.A.; Ali, K.; Roberts, A. Current uses of chlorhexidine for management of oral disease: A narrative review. J. Dent. 2020, 103, 103497. [Google Scholar] [CrossRef]
- Naureen, Z.; Medori, M.C.; Dhuli, K.; Donato, K.; Connelly, S.T.; Bellinato, F.; Gisondi, P.; Bertelli, M. Polyphenols and Lactobacillus reuteri in oral health. J. Prev. Med. Hyg. 2022, 63, E246–E254. [Google Scholar] [CrossRef] [PubMed]
- Sachelarie, L.; Scrobota, I.; Romanul, I.; Iurcov, R.; Potra Cicalau, G.I.; Todor, L. Probiotic therapy as an adjuvant in the treatment of periodontal disease: An innovative approach. Medicina 2025, 61, 126. [Google Scholar] [CrossRef]
- Xue, D.; Zhao, Y. Clinical effectiveness of adjunctive antimicrobial photodynamic therapy for residual pockets during supportive periodontal therapy: A systematic review and meta-analysis. Photodiagn. Photodyn. Ther. 2017, 17, 127–133. [Google Scholar] [CrossRef]
- Hashim, N.T.; Babiker, R.; Rahman, M.M.; Mohamed, R.; Priya, S.P.; Chaitanya, N.C.; Islam, M.S.; Gobara, B. Natural bioactive compounds in the management of periodontal disease: A comprehensive review. Molecules 2024, 29, 3044. [Google Scholar] [CrossRef]
- Guan, X.; Zhou, Y.; Chen, H.; Wang, C.; Wang, H. Antibacterial, anti-Inflammatory, and anti-osteoclastogenesis roles of allicin in periodontitis. Int. J. Clin. 2018, 11, 6721–6730. [Google Scholar]
- Madhloom, A.F.; Al-Taweel, F.B.H.; Sha, A.M.; Abdulbaqi, H.R. Antimicrobial effect of Moringa oleifera L. and red pomegranate against clinically isolated Porphyromonas gingivalis: In vitro study. Arch. Razi Inst. 2022, 77, 1405–1419. [Google Scholar] [CrossRef]
- Bakri, H.H.; Abdul Rahman, S.N.S.; Dol Bakri, Z.S.; Munadziroh, E.; Wan Harun, W.H.A. Antimicrobial activity of Ruta angustifolia L. pers against periodontal pathogen: Porphyromonas gingivalis. PeerJ. 2024, 12, e18751. [Google Scholar] [CrossRef]
- Yoon, H.J.; Kim, G.C.; Nam, S.H. Antibacterial and cytotoxic evaluation of Lespedeza cuneata extract against periodontal pathogens and human gingival cells: A novel option for periodontal therapy. Appl. Sci. 2025, 15, 190. [Google Scholar] [CrossRef]
- Wielento, A.; Lagosz-Cwik, K.B.; Potempa, J.; Grabiec, A.M. The role of gingival fibroblasts in the pathogenesis of periodontitis. J. Dent. Res. 2023, 102, 489–496. [Google Scholar] [CrossRef]
Disclaimer/Publisher’s Note: The statements, opinions and data contained in all publications are solely those of the individual author(s) and contributor(s) and not of MDPI and/or the editor(s). MDPI and/or the editor(s) disclaim responsibility for any injury to people or property resulting from any ideas, methods, instructions or products referred to in the content. |
© 2025 by the authors. Licensee MDPI, Basel, Switzerland. This article is an open access article distributed under the terms and conditions of the Creative Commons Attribution (CC BY) license (https://creativecommons.org/licenses/by/4.0/).